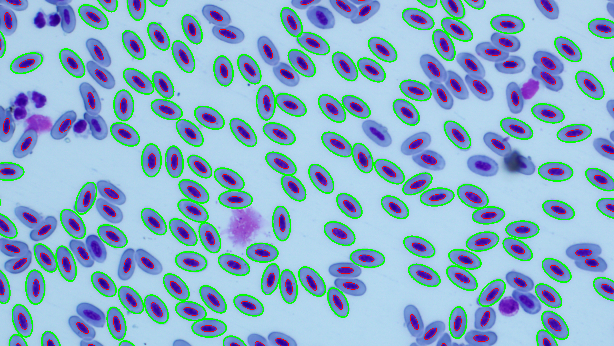
Detection of Avian Red Blood Cells

Abstract: The aim of this thesis is to develop and implement a method for the detection of avian red blood cells in microscopic images. The work will focus on applying image processing techniques to identify and measure the size and shape of the cells. The results will include statistical evaluation and visualization of the detected parameters. The outcome of the thesis will be software that can be used by biologists for automated analysis of bird blood samples.
Supervisor: Adam Novozámský